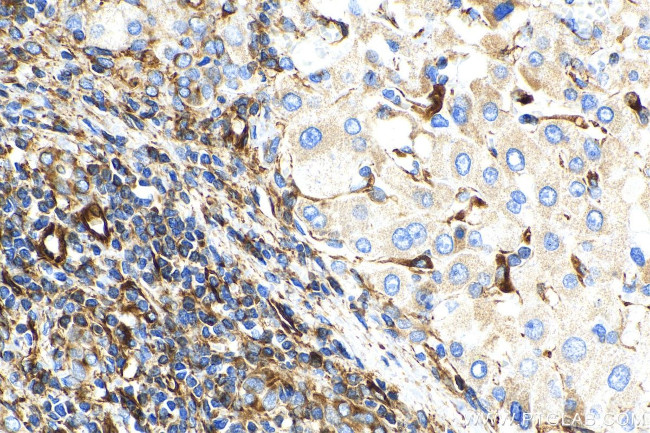
Vimentin Antibody in Immunohistochemistry (Paraffin) (IHC (P))

Search
Proteintech
Vimentin Monoclonal Antibody (3H9D1), Biotin
{{$productOrderCtrl.translations['antibody.pdp.commerceCard.promotion.promotions']}}
{{$productOrderCtrl.translations['antibody.pdp.commerceCard.promotion.viewpromo']}}
{{$productOrderCtrl.translations['antibody.pdp.commerceCard.promotion.promocode']}}: {{promo.promoCode}} {{promo.promoTitle}} {{promo.promoDescription}}. {{$productOrderCtrl.translations['antibody.pdp.commerceCard.promotion.learnmore']}}
产品信息
BIOTN60330100UL
种属反应
宿主/亚型
分类
类型
克隆号
偶联物
形式
浓度
规格
纯化类型
保存液
内含物
保存条件
运输条件
靶标信息
Vimentin is a developmentally regulated intermediate filament protein (IFP) found in cells of mesenchymal origin. It is believed to be involved with the intracellular transport of proteins between the nucleus and plasma membrane. Unlike other IFP proteins, vimentin is expressed, along with desmin, during the early stages of cellular development. During the development process, vimentin is exchanged for new, tissue-specific IFPs. Vimentin has been implicated to be involved in the rate of steroid synthesis via its role as a storage network for steroidogenic cholesterol containing lipid droplets. Vimentin phosphorylation by a protein kinase causes the breakdown of intermediate filaments and activation of an ATP and myosin light chain dependent contractile event. This results in cytoskeletal changes that facilitate the interaction of the lipid droplets within mitochondria, and subsequent transport of cholesterol to the organelles leading to an increase in steroid synthesis.
仅用于科研。不用于诊断过程。未经明确授权不得转售。
篇参考文献 (0)
生物信息学
蛋白别名: epididymis secretory sperm binding protein; FLJ36605; Hel113; RP11-124N14.1; unnamed protein product; VIM; VIME; Vimentin
基因别名: VIM
UniProt ID: (Human) P08670, (Mouse) P20152, (Rat) P31000
Entrez Gene ID: (Human) 7431, (Mouse) 22352, (Rat) 81818